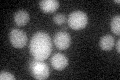
YBL059C-A
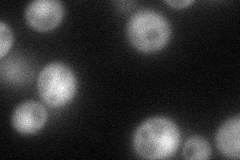
YBL059C-A
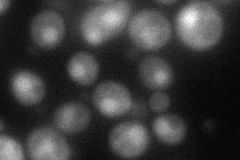
YBL059C-A
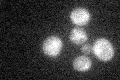
YBL059C-A

View description
Protein of the mitochondrial intermembrane space with a role in respiratory chain complex assembly or maintenance; contains twin Cx9C motifs that can form coiled coil-helix-coiled-coil helix fold
Localization:
Intensity:
Fold change:
Significance:
-
C’ GFP library in SD
cytosol23.33 -
N' NOP1pr-GFP in SD
cytosol,nucleus63.6901 -
N' TEF2pr-mCherry in SD
nucleus73.294 -
N' NATIVEpr-GFP in SD

missing0 -
N' TEF2pr-VC and Cyto-VN in SD

#N/A0 -
C’ GFP library in SD+DTT

cytosol20.270.86No -
C’ GFP library in SD+H2O2
cytosol18.420.78No -
C’ GFP library in Starvation Media

cytosol19.170.82No -
C’ GFP library on the background of Pup2-DaMP

cytosol -
C’ GFP library on the background of CCT mutant

cytosol16.65310.71356Yes
